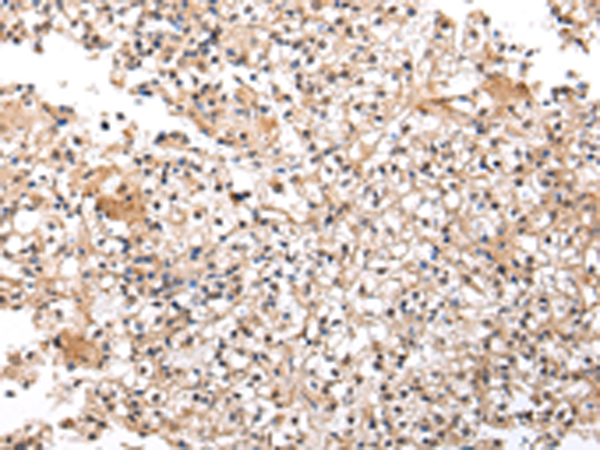

|
Background: |
The protein encoded by this gene functions as a cofactor that modulates androgen receptor-dependent transcription, and also plays a critical role in tumor necrosis factor-induced apoptosis. Expression of this gene may play a role in tumorigenesis. Alternatively spliced transcript variants encoding multiple isoforms have been observed for this gene. |
|
Applications: |
ELISA, IHC |
|
Name of antibody: |
UXT |
|
Immunogen: |
Full length fusion protein |
|
Full name: |
ubiquitously-expressed, prefoldin-like chaperone |
|
Synonyms: |
STAP1; ART-27 |
|
SwissProt: |
Q9UBK9 |
|
ELISA Recommended dilution: |
2000-5000 |
|
IHC positive control: |
Human prostate cancer |
|
IHC Recommend dilution: |
20-100 |
購物車
購物車 幫助
幫助
 021-54845833/15800441009
021-54845833/15800441009
